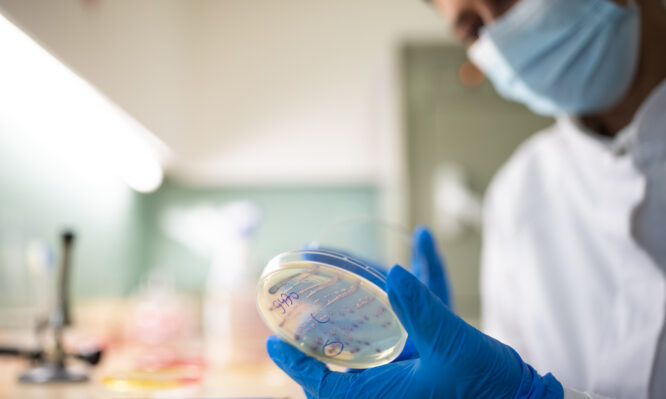
Σταφυλόκοκκος: Συναγερμός για νέο στέλεχος ανθεκτικό στα αντιβιοτικά που εξαπλώνεται στην Ευρώπη

Σταφυλόκοκκος: Συναγερμός για νέο στέλεχος ανθεκτικό στα αντιβιοτικά που εξαπλώνεται στην Ευρώπη
Ένα νέο στέλεχος του βακτηρίου που μπορεί να προκαλέσει σοβαρές λοιμώξεις στα παιδιά, αλλά δεν το πιάνουν οι συνήθειες θεραπείες, εξαπλώνεται στην Ευρώπη.
Ο MRSA (ανθεκτικός στη μεθικιλλίνη χρυσίζων σταφυλόκοκκος) είναι ένα βακτήριο που έχει εξελιχθεί σε σημείο που τα αντιβιοτικά πρώτης επιλογής δεν λειτουργούν πλέον εναντίον του, καθιστώντας πιο δύσκολη τη θεραπεία του. Μπορεί να προκαλέσει σοβαρά προβλήματα υγείας, έχοντας προκαλέσει περισσότερους από 100.000 θανάτους παγκοσμίως το 2019.
Ένα νέο στέλεχος του MRSA εντοπίστηκε στη Γερμανία και την Ολλανδία πριν από σχεδόν μια δεκαετία – και έκτοτε έχει εξαπλωθεί σε τουλάχιστον εννέα άλλες ευρωπαϊκές χώρες, σύμφωνα με νέα έρευνα του Ινστιτούτου Serum Statens (SSI) στη Δανία.
Οι επιστήμονες άρχισαν να ανησυχούν ότι το στέλεχος μπορεί να κυκλοφορεί στη Δανία, αφού 32 παιδιά και μέλη της οικογένειάς τους εμφάνισαν έλκη που προκλήθηκαν από έναν συγκεκριμένο τύπο σταφυλόκοκκου το καλοκαίρι του 2023. Έναν χρόνο αργότερα, εντόπισαν κρούσματα από το ίδιο στέλεχος σε άλλη περιοχή της χώρας.
Οι επιστήμονες υποψιάστηκαν ότι η Δανία δεν είναι το μοναδικό μέρος όπου κυκλοφορεί το νέο στέλεχος, το οποίο αποκαλούν «κλώνο» ενός άλλου τύπου MRSA επειδή έχουν κάποιες γενετικές ομοιότητες.
Όταν ανέλυσαν δείγματα σε όλη την Ευρώπη, βρήκαν τα βακτήρια σε 11 χώρες: Βέλγιο, Δανία, Φινλανδία, Γαλλία, Γερμανία, Λουξεμβούργο, Ολλανδία, Νορβηγία, Ισπανία, Σουηδία και Ηνωμένο Βασίλειο.
«Αυτός ο κλώνος, ο οποίος βρέθηκε για πρώτη φορά στη Γερμανία και την Ολλανδία το 2014, είναι ένας νέος υποτύπος» του βακτηρίου, ανέφερε σε δήλωσή του ο Andreas Petersen, ερευνητής MRSA στο SSI, ο οποίος ηγήθηκε της μελέτης.
Οι ερευνητές δημοσίευσαν τα ευρήματά τους στο περιοδικό Eurosurveillance.
Το στέλεχος είναι γενετικά παρόμοιο με μια άλλη μορφή MRSA που φαίνεται να προκαλεί μολυσματικό κηρίο, μια βακτηριακή δερματική λοίμωξη που προκαλεί σχηματισμό και έξαρση κόκκινων πληγών γύρω από τη μύτη και το στόμα.
Το μολυσματικό κηρίο, το οποίο είναι πιο συχνό σε παιδιά ηλικίας δύο έως πέντε ετών, είναι εξαιρετικά μεταδοτικό και μπορεί να εξαπλωθεί εύκολα εντός των οικογενειών. Οι εστίες συνήθως εμφανίζονται στα τέλη του καλοκαιριού και στις αρχές του φθινοπώρου.
Το μολυσματικό κηρίο συνήθως δεν είναι επικίνδυνο, αλλά σπάνιες επιπλοκές περιλαμβάνουν νεφρική βλάβη και κυτταρίτιδα, μια λοίμωξη που μπορεί να είναι απειλητική για τη ζωή εάν εξαπλωθεί στους λεμφαδένες και στην κυκλοφορία του αίματος.
Το φουσιδικό οξύ, που χρησιμοποιείται συνήθως για τη θεραπεία λοιμώξεων από εμφύσημα, δεν λειτουργεί καλά κατά του στελέχους MRSA.
Γι’ αυτό οι γιατροί σε όλη την Ευρώπη πρέπει να γνωρίζουν εάν μπορεί να εξαπλώνεται στις κοινότητές τους, ανέφεραν οι ερευνητές, θεωρώντας ότι είναι ένας συνδυασμός παραγόντων που οδηγεί στην εξάπλωσή του.
Ο ανθεκτικός στη μεθικιλλίνη χρυσίζων σταφυλόκοκκος είναι μία από τις πολλές απειλές για την υγεία που αναδύονται λόγω της αντοχής στα αντιβιοτικά. Οι λοιμώξεις από τα λεγόμενα υπερβακτήρια θα μπορούσαν να σκοτώσουν περισσότερους από 39 εκατομμύρια ανθρώπους παγκοσμίως τα επόμενα 25 χρόνια, σύμφωνα με πρόσφατη, ιστορική μελέτη.
Η αντοχή στα αντιβιοτικά έχει επίσης αντίκτυπο στο σύστημα υγείας. Συνολικά, οι 11 χώρες όπου έχει εντοπιστεί το νέο στέλεχος MRSA δαπάνησαν σχεδόν 13,3 δισεκατομμύρια δολάρια (11,4 δισεκατομμύρια ευρώ) για τη θεραπεία νοσοκομειακών ασθενών με ανθεκτικές στα φάρμακα λοιμώξεις το 2022, σύμφωνα με πρόσφατες εκτιμήσεις του Κέντρου για την Παγκόσμια Ανάπτυξη.
Οι Δανοί ερευνητές πιστεύουν ότι το νέο στέλεχος μπορεί να εξαπλώνεται απαρατήρητο και σε άλλα μέρη της Ευρώπης.
Έχει ήδη εντοπιστεί, σύμφωνα με τον Petersen εκτός νοσοκομείων και γηροκομείων, τα οποία έχουν θεσπίσει αυστηρά πρωτόκολλα για τον περιορισμό του.
Ωστόσο, όπως λέει ο ίδιος, «η εξάπλωση του MRSA στην κοινότητα είναι πιο δύσκολο να παρακολουθηθεί και να καταπολεμηθεί».
Φωτογραφία: iStock







